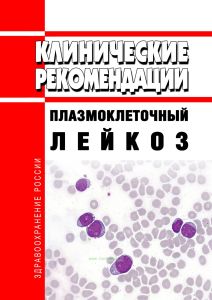
Клинические рекомендации "Плазмоклеточный лейкоз"

- Артикул:00-01103207
- ISBN: 979-5-983080-66-8
- Обложка: Мягкая обложка
- Издательство: ЦЕНТРМАГ (все книги издательства)
- Город: Москва
- Страниц: 58
- Формат: А5 (148x210 мм)
- Год: 2026
- Вес: 69 г
- Серия: Приказы Минздрава (все товары серии)
Клинические рекомендации должны быть пересмотрены не позднее 2026 года
Клинические рекомендации "Плазмоклеточный лейкоз" одобрены Минздравом России.
Плазмоклеточный лейкоз - агрессивное B-клеточное лимфопролиферативное заболевание с экстрамедуллярной диссеминацией и неблагоприятным прогнозом. Согласно классификации опухолей гематологической и лимфоидной тканей ВОЗ 5-го пересмотра плазмоклеточный лейкоз рассматривается в качестве одного из клинических вариантов множественной миеломы.
Вместе с тем, в международной классификации болезней 10 и 11 пересмотров плазмоклеточный лейкоз выделен в отдельную нозологическую единицу.
Содержание
Клинические рекомендации
Разработчик клинической рекомендации
Список сокращений
Термины и определения
1. Краткая информация по заболеванию или состоянию (группы заболеваний или состояний)
1.1. Определение заболевания или состояния (группы заболеваний или состояний)
1.2. Этиология и патогенез заболевания или состояния (группы заболеваний или состояний)
1.3. Эпидемиология заболевания или состояния (группы заболеваний или состояний)
1.4. Особенности кодирования заболевания или состояния (группы заболеваний или состояний) по Международной статистической классификации болезней и проблем, связанных со здоровьем
1.5. Классификация заболевания или состояния (группы заболеваний или состояний)
1.6. Клиническая картина заболевания или состояния (группы заболеваний или состояний)
2. Диагностика заболевания или состояния (группы заболеваний или состояний) медицинские показания и противопоказания к применению методов диагностики
Критерии установления диагноза/состояния
2.1. Жалобы и анамнез
2.2. Физикальное обследование
2.3. Лабораторные диагностические исследования
2.4. Инструментальные диагностические исследования
2.5. Иные диагностические исследования
3. Лечение, включая медикаментозную и немедикаментозную терапии, диетотерапию, обезболивание, медицинские показания и противопоказания к применению методов лечения
3.1. Показания к началу терапии и определение стратегии лечения
3.2. Лечение пациентов с впервые диагностированным ПКЛ
3.2.1. Индукционный этап терапии
3.2.2. Трансплантационный этап
3.2.3. Этап консолидирующего лечения
3.3.4. Этап поддерживающей терапии
3.4. Лечение рецидивов ПКЛ
3.5. Сопутствующая и сопроводительная терапия
Обезболивание
Диетотерапия
3.7. Определение эффективности лечения
4. Медицинская реабилитация и санаторно-курортное лечение, медицинские показания и противопоказания к применению методов медицинской реабилитации, в том числе основанных на использовании природных лечебных факторов
5. Профилактика и диспансерное наблюдение, медицинские показания и противопоказания к применению методов профилактики
6. Организация оказания медицинской помощи
Показания для плановой госпитализации
Показания для экстренной госпитализации
Показания к выписке пациента из стационара
7. Дополнительная информация (в том числе факторы, влияющие на исход заболевания или состояния)
Оценка эффективности лечения плазмоклеточного лейкоза
Критерии оценки качества медицинской помощи
Список литературы
Приложение А1. Состав рабочей группы по разработке и пересмотру клинических рекомендаций
Приложение А2. Методология разработки клинических рекомендаций
Методология сбора доказательств
Поиск в электронных базах данных
Методология валидизации рекомендаций
Описание методики валидизации рекомендаций
Порядок обновления клинических рекомендаций
Приложение А3. Справочные материалы, включая соответствие показаний к применению и противопоказаний, способов применения и доз лекарственных препаратов, инструкции по применению лекарственного препарата
Приложение А3.1 Схемы лекарственного лечения первичного плазмоклеточного лейкоза
Приложение А3.2. Рекомендации по лечению ПКЛ в период беременности
Приложение Б. Алгоритмы действий врача
Приложение В. Информация для пациента
Приложение Г1 - ГN. Шкалы оценки, вопросники и другие оценочные инструменты состояния пациента, приведенные в клинических рекомендациях
Приложение Г1.1. Шкала оценки общего состояния пациента ECOG